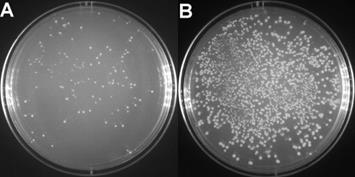
产品细节图片1

相关产品推荐更多 >
万千商家帮你免费找货
0 人在求购买到急需产品
- 详细信息
- 文献和实验
- 技术资料
- 保存条件:
室温
- 保质期:
2年
- 英文名:
Luminescent Cell Viability Assay Kit
- 库存:
844
- 供应商:
北京百奥莱博科技有限公司
- 规格:
100次|500次
特别声明:本产品及我公司所售其他产品均为科研类试剂产品,严禁用于药物、医疗及其他非科研用途。
北京百奥莱博专业生产销售YT897型细胞活力检测试剂盒(化学发光法)多少钱,我公司供应的细胞生物学试剂品类齐全,且具有优势价格,欢迎新老客户垂询订购。
名称:YT897型细胞活力检测试剂盒(化学发光法)多少钱
品牌:百奥莱博
编号:YT897
规格:100次|500次
英文名:Luminescent Cell Viability Assay Kit
产地:国产|进口
本试剂盒是一种通过化学发光法测定细胞内ATP含量从而来定量检测活细胞数目的试剂盒。本试剂盒的性能和用途与Promega公司的同类产品基本相同,对于相同的细胞样品本试剂盒的发光效果更强一些。
本试剂盒比常见的MTT、alamarBlue、Calcein-AM、WST-1、CCK-8等其它细胞活力测定方法更加简单快捷。只需把试剂盒提供的检测试剂与培养细胞等体积混合,反应10分钟后即可进行化学发光检测。无需洗涤细胞,也无需更换或去除培养液。并且化学发光非常稳定,在反应开始后的10分钟内无显著变化,30分钟内的下降不超过10%。
本试剂盒不仅适合少量样品的检测,也非常适合大量样品的高通量筛选检测。
本试剂盒线性范围广,检测灵敏度高。用96孔板进行检测时,本试剂盒在0-50,000个细胞/孔的细胞密度范围内有良好的检测效果,并且在仅有几百个细胞时仍有良好的线性关系。当细胞数量仅为50个/孔时,发光强度可达空白孔的5倍左右。
ATP,作为最重要的能量分子,在细胞的各种生理、病理过程中起着重要作用。ATP是细胞新陈代谢的一个重要指标,也是具有代谢活性细胞的重要标志性分子,并和活细胞数目成良好的线性关系。因此,ATP含量能很好地反应活细胞的数目,即本试剂盒可以通过测定ATP含量来进行细胞计数或检测细胞活力。
本试剂盒通过ATP检测细胞活力的原理参考下图。借助ATP依赖的萤光素酶催化的萤光素发光反应,ATP可以通过测定化学发光来进行定量。由于ATP含量能很好地反映活细胞的数目,而ATP含量和发光强度成正比,这样就可以简单地通过化学发光强度来计算出细胞活力或细胞数目。

对于96孔板,我们推荐使用100μl细胞培养液和100μl的检测试剂,总体积为200μl,此时本试剂盒可以进行100次检测。对于384孔板,我们推荐使用25μl细胞培养液和25μl的检测试剂,总体积为50μl,此时本试剂盒可以进行400次检测。也可以用其它体积的试剂进行检测,但细胞培养液和检测试剂体积的比例必须为1:1。
注意事项:
1. 本试剂盒的检测试剂中含有萤光素酶,反复冻融会导致其逐渐失活。尽管经测试本试剂反复冻融5次对于其检测效果无显著影响,为取得良好的使用效果,第一次解冻后可适当分装保存。反复冻融过程中,可能会导致检测试剂中出现少量沉淀,此时宜平衡至室温,并尽量溶解。如仍有残留的不溶物,可以离心去除后使用,经测试不会影响后续的检测效果。
2. 检测时需使用白色或黑色的96孔板或384孔板。如果使用普通透明的96孔板或384孔板,相邻孔之间会产生相互干扰。
3. 使用说明中提供了检测ATP标准品的方法,实际检测细胞活力时通常并不需要检测ATP标准品。
储存条件:室温,有效期2年。
想要了解更多关于YT897型细胞活力检测试剂盒(化学发光法)多少钱的价格、品牌、厂家、说明书、促销信息,请和我们联系。此外我公司还销售下面的产品:
ARB14020 植物25羟基维生素D3(25(OH)D3/25 HVD3)Elisa方法检测 Plant 25-dihydroxy vitamin d3,hvd3 ELISA KIT
F030211 HRP标记山羊抗小鼠IgA抗体 Goat Anti-Mouse IgA*HRP
4-溴联苯 Thiabendazole 92-66-0
2-萘氧乙酸钠 2,4-Dimethyl-1H-pyrrole 10042-71-4
BL1203 Mayer 苏木素染液(免疫组化)
BL1249 MarkerIDNA Ladder
004001 小牛胸腺DNA
DL-甘油醛 Indian ink 56-82-6
BTN81026 一站式生物素检测TUNEL试剂盒(DAB法) One-Stop Biotin-Based TUNEL Kit
ARB13846 猪弓形虫抗原(Tox-Ab)酶免分析
BTN90604 PCR法DNA探针标记试剂盒 PCR DNA Labeling Kit
521-31-3 Luminol 鲁米诺
14306-25-3 Phytic acid sodium salt hydrate 植酸钠
F040314 马IgG抗原 Horse IgG
肌氨酸钠 Fast red RC salt 4316-73-8
ARB13930 猪肺表面活性物质相关蛋白A(SP-A)检测服务 Porcine pulmonary surfatcant-associated protein a,sp-a ELISA KIT
二硫赤藓糖醇 NHS 6892-68-8
ARB10707 人多功能蛋白聚糖(VS)代做ELISA实验 Human versican/pg-m/pg-350,vs ELISA KIT
YT897型细胞活力检测试剂盒(化学发光法)多少钱关键词:细胞活力检测试剂盒(化学发光法),Luminescent Cell Viability Assay Kit,YT897
·GFP抗体(小鼠单抗)
编号:YT781
英文名称:mouse anti-GFP monoclonal antibody
规格:>40次
本抗体是用全长的来源于水母的GFP (green fluorescent protein)作为抗原制备得到的抗GFP小鼠单克隆抗体。本抗体用于常规的Western检测,如果稀释比例为1:1000,则至少可以检测40次。
本GFP抗体可以识别GFP以及GFP的一些突变体例如EGFP(enhanced green fluorescent protein)。
GFP或其突变体EGFP等被广泛用于基因表达效率的检测,以及和目的蛋白融合表达用于检测目的蛋白的表达和分布。本GFP抗体不仅可以检测GFP或其适当的突变体,也可以检测和GFP或其适当的突变体融合表达的蛋白。
产品组份:
GFP抗体(小鼠单抗)————40μl
Western一抗稀释液————40ml
抗体参数:
免疫原物种:水母
免疫原:水母的GFP
克隆性:单克隆
宿主:小鼠
用途:WB,IP,IF
抗体识别位点:Full length GFP
同种型:IgG2a
GFP分子量:~27kD
推荐稀释比例:WB(1:200-1000),IP(1:100),IF(1:200)
注意事项:
1. 在Western实验后,请注意回收稀释的抗体。回收的抗体在进行Western实验时至少可以重复使用10次。稀释后的抗体,包括已经使用过的稀释抗体,4℃保存。
2. 回收后重复使用的抗体,使用方法同新鲜稀释的抗体。如果在重复使用过程中发现抗体出现轻微混浊现象,可以10000g离心1-3分钟,取上清用于后续检测。如果回收的抗体出现明显的絮状物或长霉长菌等情况,则可以考虑废弃该抗体。
3. 对于本抗体,Western检测时一抗要4℃缓慢摇动过夜,如果仅短时间与一抗孵育检测效果较差。
储存条件:-20℃,有效期一年。
YT897型细胞活力检测试剂盒(化学发光法)多少钱关键词:细胞活力检测试剂盒(化学发光法),Luminescent Cell Viability Assay Kit,YT897
·T4 DNA连接酶
编号:YT029
英文名称:T4 DNA Ligase
规格:40000U|200000U
本酶可以催化粘端或平端双链DNA或RNA的5"-P末端和3"-OH末端之间以磷酸二酯键结合,该催化反应需ATP作为辅助因子。同时T4 DNA 连接酶可以修补双链DNA、双链RNA或DNA/RNA杂合物上的单链缺刻(single-strand nicks)。
用途:T4 DNA Ligase常用于DNA*(代"片")段和载体、linker或adaptor等的连接。也可以用于缺刻修复及Ligase介导的RNA检测。
来源:本T4 DNA Ligase由大肠杆菌表达,表达基因的来源为T4嗜菌体。
活性定义:One unit is defined as the amount of enzyme required to give 50% ligation of HindIII fragments of
lambda DNA in 30 min at 16℃ in 20 μl of the assay mixture containing 50 mM Tris, pH 7.5, 10 mM MgCl2, 10 mM DTT, 1 mM ATP, 25 μg/ml BSA and a 5"-DNA termini concentration of 0.12 μM (300 μg/ml)。200U等于1个Weiss unit,以Weiss unit计,本产品共200单位。
纯度:不含DNA内切酶、外切酶和磷酸酯酶,不含RNA酶,满足常规连接反应要求。
酶储存溶液:20 mM Tris, pH 7.5, 50 mM KCl, 1 mM DTT, 0.1 mM EDTA and 50% (v/v) glycerol。
10×Ligation Buffer:400 mM Tris, pH 7.8, 100 mM MgCl2, 100 mM DTT, 5 mM ATP。
失活或抑制:65℃孵育10分钟可以导致T4 DNA Ligase失活;NaCl或KCl浓度大于200mM时强烈抑制T4 DNA Ligase。
T4 DNA Ligase连接产物转化感受态后涂板LB平板的效果如上图,本品的连接产物转化感受态细菌后涂板获得的LB平板效果图。A. 双酶切后的载体自连过夜;B. 双酶切后的载体与待插入片段过夜连接。
注意事项:
1. 对于普通的转化大肠杆菌的操作,不必对连接产物进行纯化,连接产物可以直接用于转化。但用电转方法转化大肠杆菌时,通常宜先用DNA纯化试剂盒或酚氯*(代"仿")抽提方法等纯化DNA,然后再进行电转。
2. 需进行平端连接或快速连接时,推荐使用百奥莱博的快速DNA连接试剂盒(YT028/D7003)。T4 DNA Ligase可以进行平端连接,但效率较低。
3. 普通连接反应不必进行凝胶电泳观察。如果需要对于连接产物进行凝胶电泳观察,推荐先在65℃孵育10分钟使T4 DNA Ligase失活,以避免T4 DNA Ligase和DNA结合导致的条带位置迁移(band shift)。
储存条件:-20℃。
我公司正在火爆促销细胞凋亡与增殖系列产品,欢迎您的垂询选购YT897型细胞活力检测试剂盒(化学发光法)多少钱。
风险提示:丁香通仅作为第三方平台,为商家信息发布提供平台空间。用户咨询产品时请注意保护个人信息及财产安全,合理判断,谨慎选购商品,商家和用户对交易行为负责。对于医疗器械类产品,请先查证核实企业经营资质和医疗器械产品注册证情况。
文献和实验的话真的很难做下来。 我做的是胰腺癌的某个基因的沉默,有细胞培养之类的,大概要多少钱?如果做的是两个基因呢? willion1985 如果自己做的话肯定贵了,什么都得买 主要有以下东西: 1、siRNA(化学合成的siRNA,国内:600元,国外:3200左右) 2、转染试剂(Lipo2000:3000) 3、RT-PCR引物 4、qRT-PCR试剂盒(Takara:3000左右)
玻璃管中间,停留时间视玻璃管软化程度而定,由于玻璃管下端有一定重量,在受热软化后管就在重力作用下变细。用剪刀把玻璃管从中间细的地方剪断,这样一根玻璃管就成了 2 根玻璃针了,然后根据其质量好坏就可以套在微量进样器尖端给药了。 此方法只适用与没「拉管机」和拉管技术的情况下;由于是非专业操作,失败的机率很高(一下就把管烧断了或者把管烧的太细,管尖没有硬度),不过熟能生巧。假廉物美,失败 10 次有一根好的就赚了。想想,一根玻璃管多少钱,一个火机多少钱,一个拉管机多少钱,定做一根针多少钱。运用
/bbs/post/view?bid=65&id=2756447&sty=1&tpg=4&age=0 小分子SDS-PAGE电泳配方 http://www.dxy.cn/bbs/post/view?bid=65&id=2726845&sty=1&tpg=2&age=0 请教蛋白质寡聚化检测方法 http://www.dxy.cn/bbs/post/view?bid=65&id=2726510&sty=1&tpg=2&age=0 请问哪里买得到用于化学发光法western胶片曝光的带片夹的暗盒
技术资料暂无技术资料 索取技术资料









